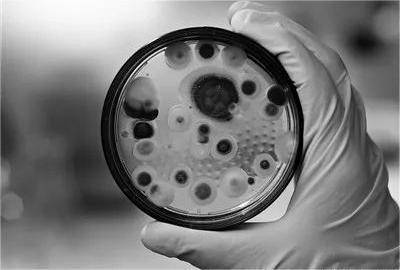
二战时期你拥有一吨青霉素,能带来多大的收益?_弗莱明_弗洛里_研究

青霉素图片弗莱明

青霉素的发明 英国科学家弗莱明
图片尺寸1080x810
弗莱明与他的青霉素
图片尺寸300x287
本品可用于由敏感菌引起的轻,中度感染,包括:呼吸系
图片尺寸1000x1000
亚历山大·弗莱明,英国细菌学家是发现青霉素的第一人.
图片尺寸1184x664
是的,他是青霉素的发现者亚历山大61弗莱明,一次偶然的失误,这位
图片尺寸640x360
你必须要知道的青霉素——"二战期间最伟大的发明"
图片尺寸640x391
健康:为何现在青霉素的使用率越来越低了?真相原来是这样!
图片尺寸551x385
神奇大发现:弗莱明偶然发现的青霉素,却改变了历史进程
图片尺寸444x304
青霉素:一个来自"意外"的伟大发现,拯救了上亿人的性命|弗莱明|细菌
图片尺寸640x594
本品适用于青霉素敏感菌株所致的轻,中度感染,肺炎球菌所致的支气管炎
图片尺寸1000x1000
青霉素无毒副作用,现在为什么不使用?
图片尺寸695x530
青霉素是谁发明的英国弗莱明发现青霉素其为固有成分
图片尺寸500x333
本品适用于青霉素敏感菌株所致的轻,中度感染,包括链球菌所致的扁桃体
图片尺寸1000x1000
青霉素丨发明最早的抗生素,在养猪中依然有不可替代的作用!
图片尺寸1280x854
弗莱明:青霉素的发明者,用自己的体液做研究,七十年拯救上亿人
图片尺寸640x360
1928年弗莱明发现青霉素,1941年上市, 标志着人类进入抗生素时代
图片尺寸1080x810
二战时期你拥有一吨青霉素,能带来多大的收益?_弗莱明_弗洛里_研究
图片尺寸400x270
本品适用于青霉素敏感菌株所致的轻,中度感染,包括链球菌所致的扁桃体
图片尺寸1000x1000
孕妇能用青霉素吗?怀孕感冒输液能用青霉素吗?
图片尺寸480x396
本品适用于青霉素敏感菌株所致的轻,中度感染,包括链球菌所致的扁桃体
图片尺寸1000x1000